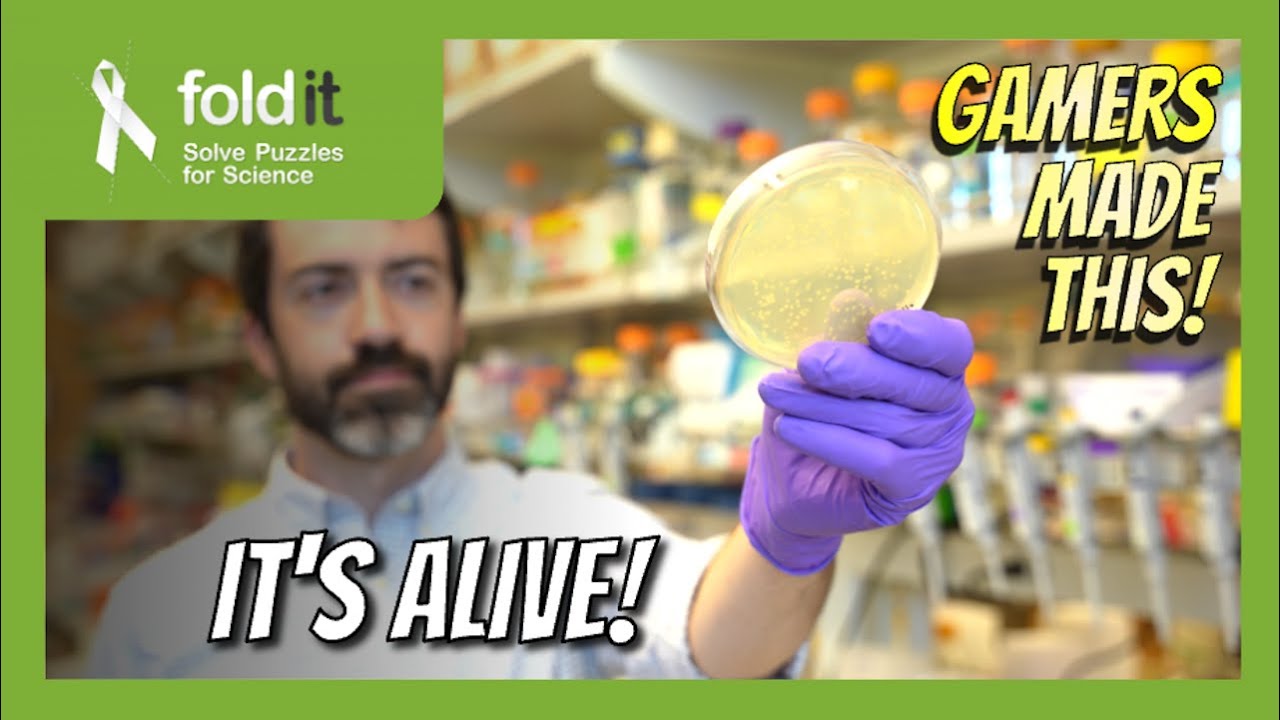
From DNA to protein (Part 2) – Lab Report 35

From DNA to protein (Part 2) – Lab Report 35
Автор: Foldit
Загружено: 2022-08-01
Просмотров: 1276
Join us in the lab to see how scientists make the proteins that players design in Foldit. In Part 2, we begin with bacterial cells and end with pure protein. Watch Part 1 here: • From DNA to protein (Part 1) – Lab Report 34
0:00 – intro
0:45 – in the lab
5:23 – design of the month
8:52 – outro
You don't have to be a scientist to do science. Download and play Foldit and you can help researchers discover new drugs for cancer, antivirals, and more. The most promising solutions are being manufactured and tested at the University of Washington Institute for Protein Design in Seattle.
Foldit is FREE and not-for-profit: https://fold.it/
This video features Foldit scientist Brian Koepnick, PhD. It was produced by Ian Haydon.
Note: Foldit is an interactive computer game and not a distributed computing project. If you would like to donate spare CPU cycles to science, please check out the Rosetta@Home project on BOINC at https://boinc.bakerlab.org/
Доступные форматы для скачивания:
Скачать видео mp4
-
Информация по загрузке:





![Пожалуй, главное заблуждение об электричестве [Veritasium]](https://image.4k-video.ru/id-video/6Hv2GLtnf2c)













